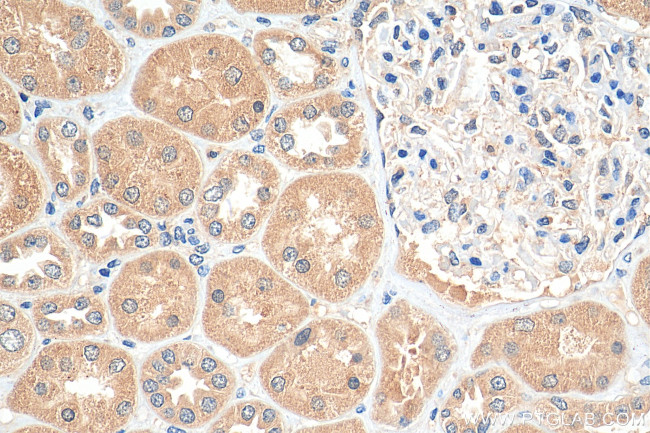
TRAPPC9/NIBP Antibody in Immunohistochemistry (Paraffin) (IHC (P))
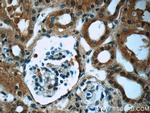
TRAPPC9/NIBP Antibody in Immunohistochemistry (Paraffin) (IHC (P))

Search
Proteintech
TRAPPC9/NIBP Monoclonal Antibody (1C4F9)
{{$productOrderCtrl.translations['antibody.pdp.commerceCard.promotion.promotions']}}
{{$productOrderCtrl.translations['antibody.pdp.commerceCard.promotion.viewpromo']}}
{{$productOrderCtrl.translations['antibody.pdp.commerceCard.promotion.promocode']}}: {{promo.promoCode}} {{promo.promoTitle}} {{promo.promoDescription}}. {{$productOrderCtrl.translations['antibody.pdp.commerceCard.promotion.learnmore']}}
产品信息
66131-1-IG
种属反应
宿主/亚型
分类
类型
克隆号
抗原
偶联物
形式
浓度
纯化类型
保存液
内含物
保存条件
运输条件
产品详细信息
Immunogen sequence: SCQENLLQD LSDDGISVSG FPLSSPFRQV VRPRVEGKPV NPPESNKAGD YSHVKTLEAV LNFKYSGGPG HTEGYYRNLS LGLHVEVEPS VFFTRVSTLP ATSTRQCHLL LDVFNSTEHE LTVSTRSSEA LILHAGECQR MAIQVDKFNF ESFPESPGEK GQFANPKQLE EERREARGLE IHSKLGICWR IPSLKRSGEA SVEGLLNQLV LEHLQLAPLQ WDVLVDGQPC DREAVAACQV GDPVRLEVRL TNRSPRSVGP FALTVVPFQD HQNGVHNYDL HDTVSFVGSS TFYLDAVQPS GQSACLGALL FLYTGDFFLH IRFHEDSTSK ELPPSWFCLP SVHVCALEAQ A (563-912 aa encoded by BC006206)
靶标信息
NIBP is a 1246 amino acid intracellular regulatory protein. Reports suggest that NIBP physically interacts with NIK, IKK (beta), but not IKK (alpha) or IKK (gamma) and thus acts as a novel enhancer of cytokine-induced NF-(kappa) B signaling pathway. Due to its neuronal expression NIBP is considered as a potential target for modulating the NF-(kappa) B signaling cascade in neuronal pathologies dependent upon abnormal activation of this pathway. NIBP is mainly expressed in brain, muscle, heart, and kidney.
仅用于科研。不用于诊断过程。未经明确授权不得转售。
篇参考文献 (0)
生物信息学
蛋白别名: IKK2 binding protein; NIK and IKK(beta) binding protein; NIK and IKK-beta binding protein; NIK- and IKBKB-binding protein; Trafficking protein particle complex subunit 9; TRAPP 120 kDa subunit; Tularik gene 1 protein
基因别名: 1810044A24Rik; 2900005P22Rik; 4632408O18Rik; IBP; IKBKBBP; KIAA1882; mKIAA1882; MRT13; NIBP; T1; TRAPPC9; TRS120; TRS130
UniProt ID: (Human) Q96Q05, (Mouse) Q3U0M1
Entrez Gene ID: (Human) 83696, (Mouse) 76510